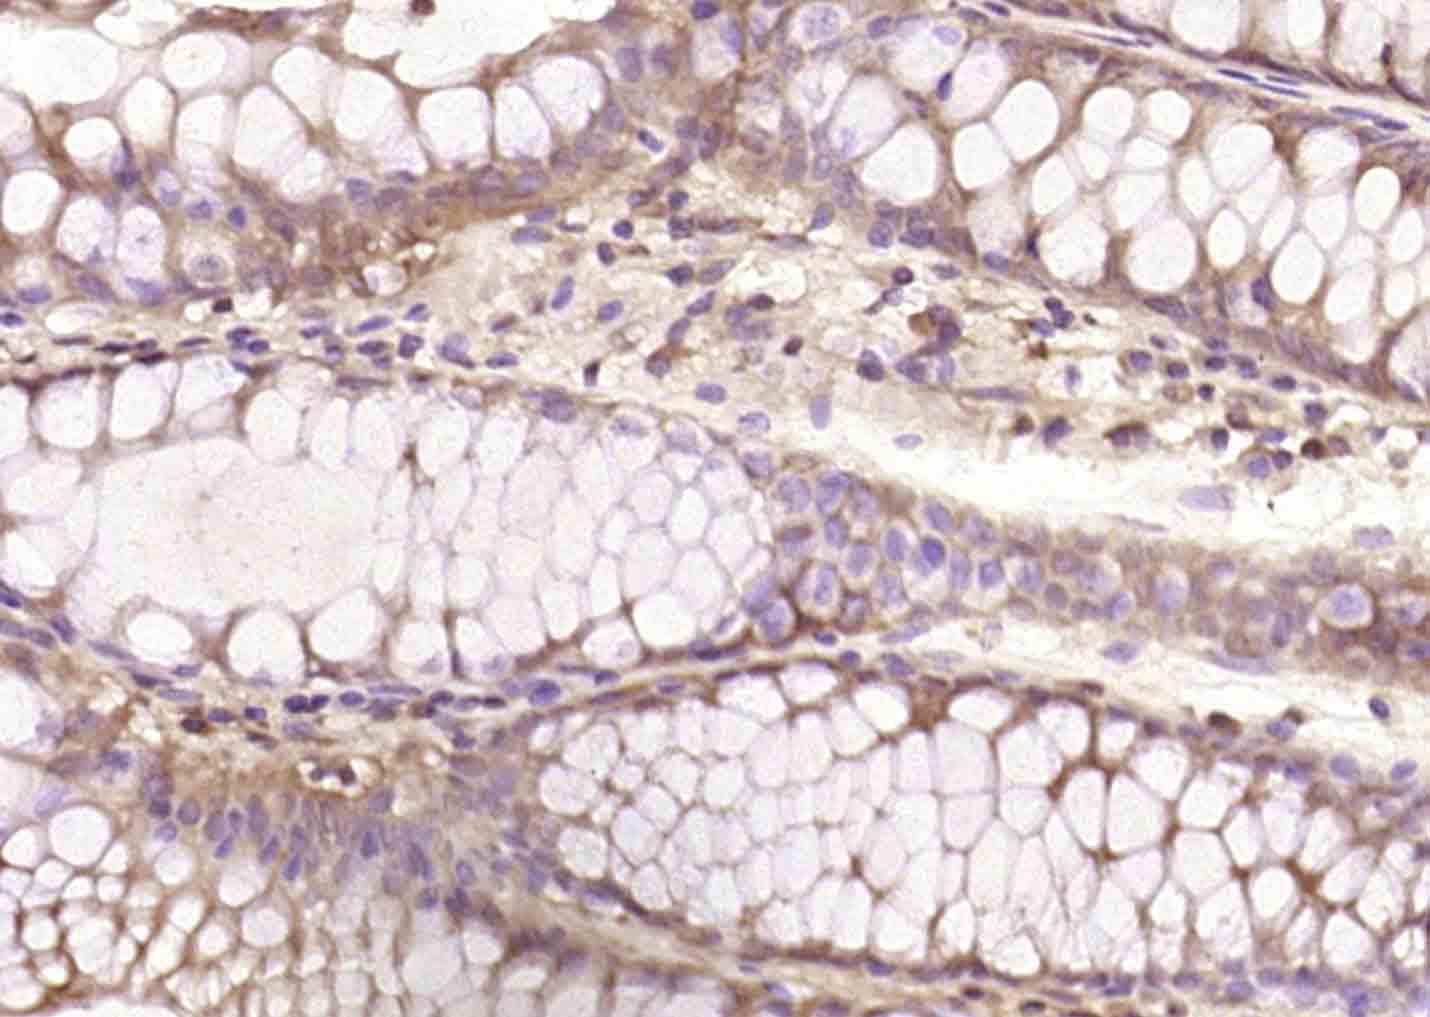
phospho-Bcl-2 (Ser70) Rabbit p

相关产品推荐更多 >

CDKN2A/p14ARF Rabbit pAb, HRP conjugated(bs-22495R-HRP)-100ul
¥2980
HLA-C Mouse mAb, Cy3 conjugated(bsm-43093M-Cy3)-100ul
¥2980
MDR1/P Glycoprotein Rabbit pAb, Cy5.5 conjugated(bs-1468R-Cy5.5)-100ul
¥2980
KDELR3 Rabbit pAb(bs-16942R)-50ul/100ul/200ul
¥1180
phospho-beta Arrestin 1 (Ser412) Recombinant Rabbit mAb(bsm-61196R)-50ul/100ul/25ul
¥800
万千商家帮你免费找货
0 人在求购买到急需产品
- 详细信息
- 文献和实验
- 技术资料
- 应用范围:
产品信息以Bioss网站为准
- 规格:
50ul/100ul/200ul
| 规格: | 50ul | 产品价格: | ¥1180.0 |
|---|---|---|---|
| 规格: | 100ul | 产品价格: | ¥1980.0 |
| 规格: | 200ul | 产品价格: | ¥2800.0 |
| 产品编号 | bs-3052R |
| 英文名称 | phospho-Bcl-2 (Ser70) Rabbit pAb |
| 中文名称 | 磷酸化Bcl-2抗体 |
| 英文别名 | Bcl2(phospho S70); p-Bcl2(phospho S70); Apoptosis regulator Bcl 2; Apoptosis regulator Bcl2; AW986256; B cell CLL/lymphoma 2; B cell leukemia/lymphoma 2; B cell lymphoma 2; Bcl 2; Bcl-2; Bcl2; BCL2 protein; C430015F12Rik; D630044D05Rik; D830018M01Rik; Leukemia/lymphoma, B-cell, 2; Oncogene B-cell leukemia 2; BCL2_HUMAN. |
| 产品应用 | IHC-P=1:100-500, IHC-F=1:100-500, IF=1:100-500, Flow-Cyt=1ug/test Not yet tested in other applications. |
| 交叉反应 | Human (Mouse, Rat, Dog, Rabbit) |
| 抗体来源 | Rabbit |
| 免疫原 | KLH conjugated Synthesised phosphopeptide derived from rat Bcl-2 around the phosphorylation site of Ser70 |
| 亚型 | IgG |
| 性状 | Liquid |
| 纯化方法 | affinity purified by Protein A |
| 克隆类型 | Polyclonal |
| 理论分子量 | 26 kDa |
| 浓度 | 1mg/ml |
| 储存液 | 0.01M TBS (pH7.4) with 1% BSA, 0.02% Proclin300 and 50% Glycerol. |
| 研究领域 | Cancer > Cancer Metabolism > Cellular metabolic process Cancer > Cancer Metabolism > Response to hypoxia Cancer > Cell Death > Apoptosis > Apoptosis Markers > Bcl 2 family Cancer > Cell Death > Apoptosis > Metabolism Cancer > Invasion/microenvironment > Apoptosis > Bcl 2 family Cancer > Oncoproteins/suppressors > Oncoproteins > Cell survival & death Cancer > Tumor biomarkers > Oncoproteins Cell Biology > Apoptosis > Intracellular > Bcl2 Family Kits/ Lysates/ Other > Kits > ELISA Kits > ELISA Kits > Apoptosis marker and proteins ELISA kits Metabolism > Pathways and Processes > Metabolism processes > Apoptosis Metabolism > Pathways and Processes > Metabolism processes > Hypoxia Metabolism > Pathways and Processes > Mitochondrial Metabolism > Mitochondrial markers Metabolism > Types of disease > Cancer Signal Transduction > Metabolism > Mitochondrial |
| 亚基 | Forms homodimers, and heterodimers with BAX, BAD, BAK and Bcl-X(L). Heterodimerization with BAX requires intact BH1 and BH2 motifs, and is necessary for anti-apoptotic activity. Interacts with EI24 (By similarity). Also interacts with APAF1, BBC3, BCL2L1, BNIPL, MRPL41 and TP53BP2. Binding to FKBP8 seems to target BCL2 to the mitochondria and probably interferes with the binding of BCL2 to its targets. Interacts with BAG1 in an ATP-dependent manner. Interacts with RAF1 (the 'Ser-338' and 'Ser-339' phosphorylated form). Interacts (via the BH4 domain) with EGLN3; the interaction prevents the formation of the BAX-BCL2 complex and inhibits the anti-apoptotic activity of BCL2. Interacts with G0S2; this interaction also prevents the formation of the anti-apoptotic BAX-BCL2 complex. |
| 亚细胞定位 | Mitochondrion outer membrane; Single-pass membrane protein. Nucleus membrane; Single-pass membrane protein. Endoplasmic reticulum membrane; Single-pass membrane protein. |
| 组织特异性 | Expressed in a variety of tissues. |
| 翻译后修饰 | Phosphorylation/dephosphorylation on Ser-70 regulates anti-apoptotic activity. Growth factor-stimulated phosphorylation on Ser-70 by PKC is required for the anti-apoptosis activity and occurs during the G2/M phase of the cell cycle. In the absence of growth factors, BCL2 appears to be phosphorylated by other protein kinases such as ERKs and stress-activated kinases. Phosphorylated by MAPK8/JNK1 at Thr-69, Ser-70 and Ser-87, wich stimulates starvation-induced autophagy. Dephosphorylated by protein phosphatase 2A (PP2A). Proteolytically cleaved by caspases during apoptosis. The cleaved protein, lacking the BH4 motif, has pro-apoptotic activity, causes the release of cytochrome c into the cytosol promoting further caspase activity. Monoubiquitinated by PARK2, leading to increase its stability. |
| 相似性 | Belongs to the Bcl-2 family. |
| 功能 | Suppresses apoptosis in a variety of cell systems including factor-dependent lymphohematopoietic and neural cells. Regulates cell death by controlling the mitochondrial membrane permeability. Appears to function in a feedback loop system with caspases. Inhibits caspase activity either by preventing the release of cytochrome c from the mitochondria and/or by binding to the apoptosis-activating factor (APAF-1). |
| 保存条件 | Shipped at 4℃. Store at -20℃ for one year. Avoid repeated freeze/thaw cycles. |
| 注意事项 | This product as supplied is intended for research use only, not for use in human, therapeutic or diagnostic applications. |
| 背景资料 | The Bcl-2 gene was isolated at the chromosomal breakpoint of t(14;18)-bearing follicular B cell lymphomas(1,2).Bcl-2 blocks cell death following a variety of stimuli and confers a death-sparing effect to certain hematopoietic cell lines following growth factor withdrawal (3,5).Bcl-2 appears to function in several subcellular locations yet lacks any known motifs that would confer insight into its mechanism of action (6,7).A more recently identified protein,designated Bax p21(i.e., Bcl-associated X protein ),has extensive amino acid homology with Bcl-2 and both homodimerizes and forms heterodimers with Bcl-2(8). Overexpression of Bax accelerates apoptotic death induced by cytokine deprivation in an IL-3 dependent cell line and Bax also counters the death repressor activty of Bcl-2(8). |
| 应用 | 推荐稀释比例 |
| {IHC-P} | {1:100-500} |
| {IHC-F} | {1:100-500} |
| {IF} | {1:100-500} |
| {Flow-Cyt} | {1ug/test} |

Primary Antibody (green line): Rabbit Anti-Phospho-Bcl-2 (Ser70) antibody (bs-3052R)
Dilution: 1μg /10^6 cells;
Isotype Control Antibody (orange line): Rabbit IgG .
Secondary Antibody : Goat anti-rabbit IgG-AF488
Dilution: 1μg /test.
Protocol
The cells were fixed with 4% PFA (10min at room temperature)and then permeabilized with 0.1%PBST for 20 min at room temperature. The cells were then incubated in 5%BSA to block non-specific protein-protein interactions for 30 min at room temperature .Cells stained with Primary Antibody for 30 min at room temperature. The secondary antibody used for 40 min at room temperature. Acquisition of 20,000 events was performed.

Primary Antibody (green line): Rabbit Anti-Phospho-Bcl-2 (Ser70) antibody (bs-3052R)
Dilution: 3μg /10^6 cells;
Isotype Control Antibody (orange line): Rabbit IgG .
Secondary Antibody : Goat anti-rabbit IgG-AF647
Dilution: 3μg /test.
Protocol
The cells were fixed with 4% PFA (10min at room temperature)and then permeabilized with 90% ice-cold methanol for 20 min at-20℃. The cells were then incubated in 5%BSA to block non-specific protein-protein interactions for 30 min at at room temperature .Cells stained with Primary Antibody for 30 min at room temperature. The secondary antibody used for 40 min at room temperature. Acquisition of 20,000 events was performed.
风险提示:丁香通仅作为第三方平台,为商家信息发布提供平台空间。用户咨询产品时请注意保护个人信息及财产安全,合理判断,谨慎选购商品,商家和用户对交易行为负责。对于医疗器械类产品,请先查证核实企业经营资质和医疗器械产品注册证情况。
文献和实验[IF={{ 5.47 }}] {Yan, Jia-Qing, et al. "Overexpression of Human E46K Mutant α-Synuclein Impairs Macroautophagy via Inactivation of JNK1-Bcl-2 Pathway." Molecular Neurobiology (2014): 1-17.} {WB} {="Rat"}
[IF={{ 3.375 }}] {Shuyu Fang. et al. All-trans-retinoic acid inhibits the malignant behaviors of hepatocarcinoma cells by regulating autophagy. Am J Transl Res. 2020; 12(10): 6793–6810} {IF} {Mouse, Human}
:使用 Anti-phospho-Akt (Ser473) Rabbit mAb 对石蜡包埋的人乳腺癌组织进行免疫组织化学分析。(图 A)使用免疫组化试剂盒M&R HRP/DAB Detection IHC Kit,抗体 1:100 稀释;(图 B) 采用普通免疫组化试剂盒,抗体 1:25 稀释。 图 6 免疫组化实验检测 Erk1/2 表达 注:使用 Anti-Erk1/2 Mouse mAb与p44/42 MAPK (Erk1/2)Rabbit mAb 对正常小鼠心脏组织进行免疫
at 10, 25, and 50 μM). At 24 h post-treatment, celllysates were obtained; SDS-PAGE and Western blotting were performed as described in Section 3, Methods. AR-A014418dose-dependent decreases of phospho-β-catenin (Ser33/37) and phospho-glycogen synthase
(Ser473)(193H12)Rabbit mAb,1:300,稀释,二抗是驴抗兔,1:2000,我是实验室的新手,刚呆俩月,受 此挫折,一头雾水,请过来人或者有经验的同学帮忙解答怎样解决,非常感谢! 碧峤 pAkt有两个位点,Ser473和Thr308,其中Ser473相对容易显色。如果显色失败,可能的原因:1 上样量过少,我们一般都是30μg;2 一抗孵育时间过短,我们一般24h~48h;3 一抗是否工作有待排除 米宝
技术资料暂无技术资料 索取技术资料






